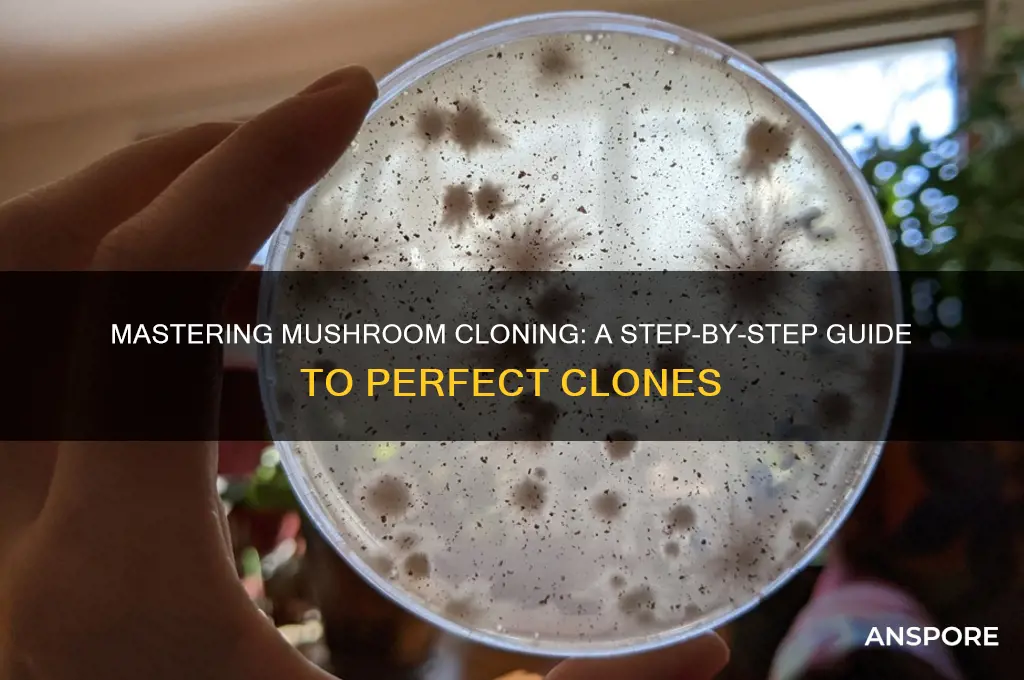
how to take a mushroom clone

Taking a mushroom clone is a precise and rewarding process that allows cultivators to replicate a specific mushroom strain with its unique genetic traits. This method involves carefully extracting a small piece of mycelium—the vegetative part of the fungus—from a healthy, mature mushroom or its growing substrate. The sample is then transferred to a sterile environment, such as a petri dish with agar or a test tube with liquid culture, to encourage growth. Proper sterilization techniques are crucial to prevent contamination, ensuring the cloned mycelium thrives without competition from unwanted microorganisms. Cloning is particularly useful for preserving desirable traits like high yields, potency, or resistance to diseases, making it an essential skill for both hobbyists and professional mushroom growers.
| Characteristics | Values |
|---|---|
| Method | Tissue culture, agar cloning, or grain transfer |
| Tools Needed | Scalpel, alcohol wipes, sterile gloves, petri dishes, agar, pressure cooker, mushroom culture syringe |
| Sterility | Critical; all tools and workspace must be sterilized |
| Mushroom Type | Works best with mycelium-producing species (e.g., oyster, shiitake, lion's mane) |
| Tissue Source | Healthy, actively growing mycelium or fresh mushroom tissue |
| Agar Medium | Malt extract agar (MEA) or potato dextrose agar (PDA) |
| Incubation | 22-26°C (72-78°F), dark environment, 7-14 days |
| Contamination Risk | High; monitor for mold, bacteria, or competing fungi |
| Success Rate | 60-90% depending on sterility and technique |
| Storage | Cloned mycelium can be stored on agar slants or in culture syringes at 4°C (39°F) |
| Legal Considerations | Check local laws; some mushroom species are protected or regulated |
| Time Frame | 2-4 weeks from cloning to usable mycelium culture |
| Alternative Methods | Liquid culture cloning, grain spawn cloning |
| Common Mistakes | Poor sterilization, using diseased tissue, incorrect incubation conditions |
Explore related products
What You'll Learn
- Prepare Sterile Tools: Autoclave or sterilize scalpel, alcohol wipes, and containers to prevent contamination
- Select Healthy Tissue: Choose firm, disease-free mushroom mycelium or primordia for cloning
- Isolate Mycelium: Carefully cut and transfer tissue to agar or grain spawn medium
- Incubate Properly: Maintain optimal temperature (22-26°C) and humidity in a dark environment
- Transfer to Substrate: Once colonized, move mycelium to bulk substrate for fruiting

Prepare Sterile Tools: Autoclave or sterilize scalpel, alcohol wipes, and containers to prevent contamination
To successfully take a mushroom clone, ensuring all tools are sterile is paramount to prevent contamination. Begin by gathering the necessary tools: a scalpel, alcohol wipes, and containers for storing the cloned tissue. These items must be thoroughly sterilized to eliminate any microorganisms that could compromise the cloning process. The most effective method for sterilization is using an autoclave, a device that uses steam under pressure to kill all forms of microbial life. If an autoclave is not available, alternative sterilization methods such as boiling or using a pressure cooker can be employed, though they may be less reliable.
Before sterilization, clean all tools with soap and water to remove any visible debris. This preliminary cleaning step ensures that the sterilization process is more effective. Once cleaned, wrap the scalpel and containers in aluminum foil or place them in autoclave bags if using an autoclave. This protects the tools from dust and other contaminants during the sterilization process. For alcohol wipes, ensure they are individually sealed and sterile; if not, they should also be sterilized using the autoclave or another appropriate method.
When using an autoclave, follow the manufacturer’s instructions for loading and operating the machine. Typically, the autoclave cycle involves heating the tools to 121°C (250°F) at 15 psi for at least 30 minutes. This duration ensures that all bacteria, fungi, and spores are destroyed. After the cycle is complete, allow the autoclave to cool down naturally to avoid contamination from the external environment. If boiling or using a pressure cooker, ensure the tools are fully submerged in water and heated for at least 20 minutes to achieve sterilization.
Once the tools are sterilized, handle them with care to maintain their sterile condition. Use sterile gloves or flame-sterilized tweezers to remove the tools from the autoclave or containers. Place the scalpel and containers in a clean, sterile workspace, and keep them covered until ready for use. Alcohol wipes should be stored in a sealed, sterile container to prevent contamination. Ensure the workspace itself is clean and free from potential contaminants, such as dust or mold spores.
Finally, prepare the alcohol wipes for immediate use by ensuring they are easily accessible but remain sealed until needed. When taking the mushroom clone, use the sterile scalpel to carefully excise a small piece of mushroom tissue, and immediately wipe the scalpel with an alcohol wipe between cuts to prevent cross-contamination. Place the cloned tissue into the sterile container, sealing it promptly to maintain a sterile environment. By meticulously preparing and handling sterile tools, you significantly reduce the risk of contamination, increasing the chances of a successful mushroom clone.
Avoid Stumbles: Dozo Mushroom Extract Benefits and Safe Usage Tips
You may want to see also

Select Healthy Tissue: Choose firm, disease-free mushroom mycelium or primordia for cloning
When selecting healthy tissue for mushroom cloning, the first step is to identify firm and robust mycelium or primordia. Mycelium, the vegetative part of the fungus, should appear white, vibrant, and free from any discoloration or signs of decay. Primordia, the early stage of mushroom formation, should be small, compact, and show no signs of abnormal growth. Avoid any tissue that looks mushy, brown, or has a foul odor, as these are indicators of contamination or disease. Healthy tissue is crucial for successful cloning, as it ensures the new culture will grow vigorously and remain free from pathogens.
Inspect the mushroom substrate or growing medium for any visible signs of pests, mold, or bacterial infections. Healthy mycelium should be actively colonizing the substrate without competition from foreign organisms. Use a magnifying glass if necessary to detect tiny pests or early stages of contamination. If the substrate appears compromised, it is best to discard it and select tissue from a different, uncontaminated area. The goal is to isolate the purest and most vigorous mycelium or primordia to guarantee the clone’s vitality.
Firmness is a key indicator of healthy tissue. Gently press the mycelium or primordia with a sterile tool; it should bounce back slightly, indicating turgor and good health. Soft or spongy tissue may be waterlogged or decaying, making it unsuitable for cloning. Similarly, overly dry or brittle tissue lacks the necessary moisture and nutrients to support growth. Aim for tissue that feels resilient and alive, as this will provide the best foundation for a successful clone.
Disease-free tissue is non-negotiable for cloning. Examine the selected area for any abnormalities such as lesions, spots, or unusual growth patterns. These could be symptoms of fungal, viral, or bacterial infections. Even if the issue seems minor, it can spread to the new clone and compromise its health. Always err on the side of caution and choose tissue from a completely healthy source. If you’re working with a large culture, take samples from multiple areas to increase the chances of finding pristine tissue.
Finally, ensure the selected tissue is at the right stage of development. For mycelium, choose areas that are actively growing but not yet overgrown, as overly mature mycelium may be less viable. For primordia, select those that are just beginning to form, as they are more likely to adapt to new conditions. Proper timing ensures the tissue is in its prime state for cloning. Once you’ve identified the ideal tissue, use sterile techniques to excise it, minimizing the risk of contamination during the cloning process.
Reishi Mushrooms: Blood Thinning Superfood?
You may want to see also

Isolate Mycelium: Carefully cut and transfer tissue to agar or grain spawn medium
To isolate mycelium for mushroom cloning, begin by sterilizing your workspace and tools to prevent contamination. Use a flame or alcohol to sterilize your scalpel or blade, and ensure your hands are clean. Select a healthy, disease-free mushroom as your source. Gently remove a small piece of tissue from the inner stem or the base of the mushroom cap, where mycelium is most concentrated. The goal is to capture viable mycelium without introducing contaminants. Precision is key, so make your cut clean and deliberate, avoiding any damaged or discolored areas.
Once you’ve obtained the tissue sample, prepare your agar or grain spawn medium. If using agar, ensure it has cooled to a temperature that won’t kill the mycelium (around 50°C or 122°F). For grain spawn, sterilize the grains and allow them to cool in a sterile environment. Using your sterilized tool, carefully transfer the tissue sample onto the surface of the agar or into the grain spawn. If using agar, place the tissue in the center of the Petri dish, ensuring it makes good contact with the medium. For grain spawn, gently press the tissue into the grains, burying it slightly to encourage colonization.
After transferring the tissue, seal the agar dish or grain spawn container to maintain sterility. Label the container with the date and mushroom species for future reference. Place the container in a warm, dark environment with consistent temperatures between 21°C and 27°C (70°F and 80°F) to promote mycelium growth. Regularly inspect the medium for signs of contamination, such as mold or unusual colors, and discard if necessary. Mycelium should begin to grow within 7 to 14 days, depending on the species and conditions.
When using agar, once the mycelium has fully colonized the surface (usually in 2-4 weeks), you can transfer it to grain spawn or another substrate to expand the culture. To do this, cut a small piece of the colonized agar and inoculate the grain spawn using the same sterile techniques. For grain spawn, once the mycelium has fully colonized the grains (typically in 2-3 weeks), it can be used to inoculate bulk substrate for fruiting. Patience and attention to detail are crucial during this stage to ensure a successful clone.
Throughout the process, maintain strict sterile conditions to avoid contamination, as even a small amount of bacteria or mold can ruin your clone. If contamination occurs, start over with fresh materials and ensure your workspace is thoroughly sterilized. Isolating mycelium is a delicate but rewarding step in mushroom cloning, as it allows you to preserve and propagate specific mushroom strains with desirable traits. With practice, you’ll become more adept at handling the tissue and maintaining sterile conditions, increasing your chances of success.
How Mushrooms Enhance Gameplay in Merge Dragons: Tips and Tricks
You may want to see also
Explore related products
$14.99

Incubate Properly: Maintain optimal temperature (22-26°C) and humidity in a dark environment
Incubating mushroom clones properly is a critical step in ensuring successful growth and development. To achieve this, maintaining the optimal temperature range of 22-26°C (72-78°F) is essential. This temperature range mimics the natural environment in which mushrooms thrive, promoting healthy mycelium growth. You can use a thermometer to monitor the temperature, placing it near the incubation area to ensure accuracy. If the temperature deviates from the optimal range, consider using heating mats, insulation, or air conditioning to adjust it accordingly. Consistency is key, as fluctuations can stress the mycelium and hinder growth.
Humidity control is another crucial aspect of proper incubation. Mushrooms require a high-humidity environment, typically around 90-95%, to prevent the mycelium from drying out. To maintain this level, use a hygrometer to monitor humidity and employ techniques such as misting the incubation area, using a humidifier, or placing a tray of water near the clones. Be cautious not to over-saturate the environment, as excessive moisture can lead to contamination. Regularly check the humidity levels and adjust as needed to create an ideal atmosphere for the mushroom clones.
Creating a dark environment is equally important during incubation. Mushrooms are sensitive to light, especially during the initial growth stages, as it can disrupt their natural growth patterns. To ensure darkness, incubate the clones in a closed container or room with opaque walls, or use light-proof materials to cover the incubation area. Avoid using transparent or translucent containers, as they may allow light to penetrate and affect the mycelium. If using a grow tent or room, ensure all light sources are sealed or turned off during the incubation period.
When setting up the incubation area, choose a location that is free from drafts, direct sunlight, and temperature extremes. A stable, controlled environment will significantly improve the chances of successful cloning. Consider using an incubation chamber or a modified storage container with proper ventilation to maintain optimal conditions. Ensure the area is clean and sanitized to minimize the risk of contamination, which can quickly ruin the cloning process. Regularly inspect the incubation area for any signs of mold, bacteria, or pests, and take corrective action immediately if any issues arise.
Throughout the incubation period, monitor the clones regularly but minimize disturbances to the environment. Gently inspect the mycelium for signs of growth, contamination, or stress, being careful not to disrupt the delicate structures. Keep a detailed log of temperature, humidity, and any observations to track progress and identify potential issues early. With proper incubation, the mycelium should begin to colonize the substrate within 7-14 days, depending on the mushroom species and environmental conditions. Patience and attention to detail during this stage will greatly contribute to the overall success of taking a mushroom clone.
Creating Mushroom Spores Incubator: A Step-by-Step Guide
You may want to see also

Transfer to Substrate: Once colonized, move mycelium to bulk substrate for fruiting
Once your mycelium has fully colonized the spawn jar or bag, it’s time to transfer it to a bulk substrate to initiate fruiting. This step is critical for the mushroom cloning process, as it provides the mycelium with the nutrients and environment needed to produce mushrooms. Begin by preparing your bulk substrate, which can be a mixture of materials like straw, wood chips, or coconut coir, depending on the mushroom species. Sterilize or pasteurize the substrate to eliminate contaminants, ensuring a clean environment for the mycelium to thrive. Allow the substrate to cool to room temperature before use, as excessive heat can damage the mycelium.
Next, prepare your workspace to maintain sterile conditions. Clean the area thoroughly and use a still air box or a laminar flow hood if available. Gather your tools, including gloves, a scalpel or clean scissors, and alcohol for sterilization. Open your spawn jar or bag carefully, minimizing exposure to contaminants. Break up the fully colonized mycelium into smaller chunks to increase the surface area for contact with the bulk substrate. This step helps accelerate colonization of the new substrate.
Transfer the mycelium chunks to the prepared bulk substrate in a clean container or monotub. Distribute the mycelium evenly throughout the substrate, ensuring good contact between the mycelium and the material. Mix gently but thoroughly to integrate the mycelium without damaging it. The goal is to create a uniform mixture that allows the mycelium to spread efficiently. Once mixed, cover the container with a lid or breathable material like microns-rated filter patches to maintain humidity and prevent contamination.
Place the container in a dark, temperature-controlled environment suitable for the mushroom species you’re cultivating. Monitor the humidity and ensure proper air exchange to prevent the buildup of carbon dioxide, which can inhibit fruiting. Over the next few weeks, the mycelium will colonize the bulk substrate. Once fully colonized, introduce fruiting conditions by exposing the substrate to light, adjusting humidity, and maintaining optimal temperature. This triggers the mycelium to begin forming mushroom pins, which will eventually develop into mature fruiting bodies.
Finally, maintain a consistent environment during the fruiting stage, as fluctuations can stress the mycelium and reduce yields. Harvest mushrooms as they mature, and consider reusing the partially spent substrate for another flush if the species allows it. This transfer to bulk substrate is a pivotal step in the mushroom cloning process, bridging the gap between colonization and fruiting, and requires attention to detail to ensure success.
Mushroom Extract Powder: Nature's Superfood Boost
You may want to see also
Frequently asked questions
Mushroom cloning is the process of taking a tissue sample from a healthy mushroom to grow an identical genetic copy. It’s useful for preserving desirable traits, ensuring consistent yields, and avoiding contamination from spores.
You’ll need a sterile scalpel or blade, agar plates or liquid culture media, a sterile workspace (glove box or still air box), alcohol for sterilization, and a flame source for sterilizing tools.
Clean your workspace with 70% isopropyl alcohol, sterilize tools by passing them through a flame, and ensure your hands are sanitized. Work quickly and avoid exposing open containers to the air to minimize contamination.
Use a small piece of the mushroom’s tissue, such as the stem base or gill area. Sterilize your blade, cut the tissue, and gently place it onto the agar plate or into the liquid culture, ensuring it doesn’t touch any non-sterile surfaces.























![Boomer Shroomer Inflatable Monotub Kit, Mushroom Growing Kit Includes a Drain Port, Plugs & Filters, Removeable Liner [Patent No: US 11,871,706 B2]](https://m.media-amazon.com/images/I/61K9zwzRQxL._AC_UL320_.jpg)



















